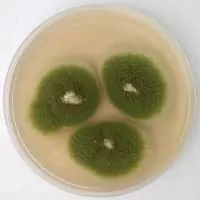
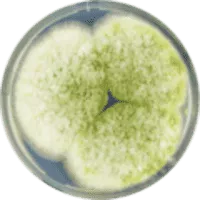
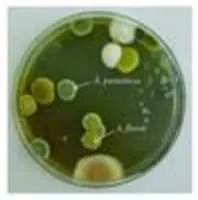
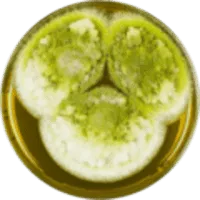

Aspergillus Parasiticus
| Use attributes for filter ! | |
| Higher classification | Aspergillus |
|---|---|
| Order | Eurotiales |
| Rank | Species |
| Kingdom | Fungi |
| Family | Trichocomaceae |
| Date of Reg. | |
| Date of Upd. | |
| ID | 1177776 |
About Aspergillus Parasiticus
Aspergillus parasiticus is a fungus belonging to the genus Aspergillus. This species is an unspecialized saprophytic mold, mostly found outdoors in areas of rich soil with decaying plant material as well as in dry grain storage facilities.